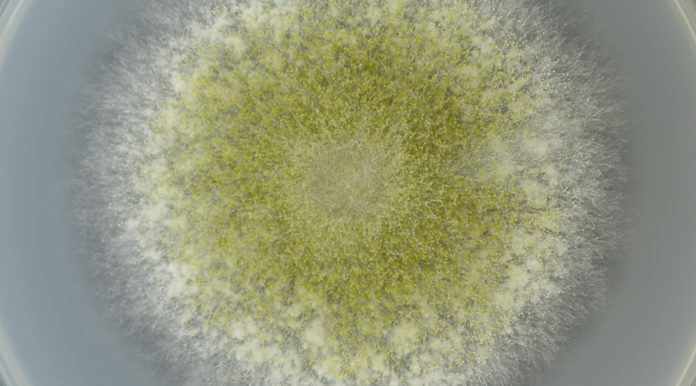

タカヂアスターゼが産業技術史資料情報センター(国立科学博物館)が選定する重要科学技術史資料(未来技術遺産)に登録されました。高峰譲吉博士が麹菌の純粋培養を可能にし、そこから調製された消化酵素がタカヂアスターゼです。今から約120年前に世界で初めて産業化された微生物酵素剤です(1894年/明治27年)。高峰博士はその後もアドレナリンを発見するなどの業績をあげます。一方、タカヂアスターゼの特許で莫大な利益を得る事になります。その後、博士は三共商会(現・第一三共)の初代社長に就任し、その後も日米の架け橋となるべく尽力されます。まさにイノベーティブでグローバルな研究者といえるでしょう。